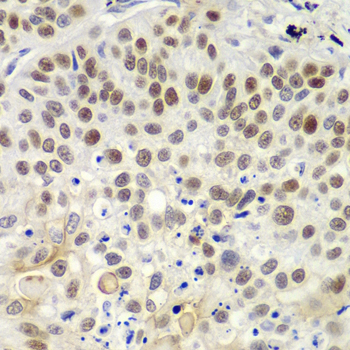

For quotations, please use our online quotation form, and you may also contact us by
service@kendallscientific.com
+1-888.733.6849 (Toll-free)
+1-617.299.7367 (Int’l))
+1-888.733.6849
Our customer service representatives are available 24 hours, Monday through Friday to assist you.| Reactivity | Human Mouse Rat |
| Tested applications | WB IHC IF |
| Recommended Dilution | WB 1:500 - 1:2000 IHC 1:50 - 1:200 IF 1:20 - 1:100 |
| Calculated MW | 153kDa |
| Observed MW | Refer to Figures |
| Immunogen | Recombinant protein of human MSH6 |
| Storage Buffer | Store at -20℃. Avoid freeze / thaw cycles. Buffer: PBS with 0.02% sodium azide, 50% glycerol, pH7.3. |
| Concentration | bef |
| Synonym | MSH6;GTBP;HNPCC5;HSAP ; |

Western blot analysis of extracts of various cell lines, using MSH6 antibody.
Immunohistochemistry of paraffin-embedded human lung cancer using MSH6 antibody at dilution of 1:100 (400x lens).

Immunohistochemistry of paraffin-embedded human colon using MSH6 antibody at dilution of 1:100 (400x lens).

Immunohistochemistry of paraffin-embedded human oophoroma using MSH6 antibody at dilution of 1:100 (400x lens).

Immunohistochemistry of paraffin-embedded human kidney cancer using MSH6 antibody at dilution of 1:100 (400x lens).

Immunohistochemistry of paraffin-embedded human amygdalitis using MSH6 antibody at dilution of 1:100 (400x lens).

Immunofluorescence analysis of HeLa cell using MSH6 antibody. Blue: DAPI for nuclear staining.

Immunofluorescence analysis of GFP-RNF168 transgenic U2OS cell using MSH6 antibody. Green:GFP-RNF168 fusion protein expression for DNA damage marker.Blue: DAPI for nuclear staining.RNF168(GFP) can be used to mark cells damaged by UV-A laser for they always gather around DNA damage region.

Immunofluorescence analysis of A549 cell using MSH6 antibody.

Immunofluorescence analysis of A549 cell using MSH6 antibody.
The DNA mismatch repair system (MMR) repairs post-replication DNA, inhibits recombination between nonidentical DNA sequences, and induces both checkpoint and apoptotic responses following certain types of DNA damage (1). MSH2 (MutS homologue 2) forms the hMutS-α dimer with MSH6 and is an essential component of the mismatch repair process. hMutS-α is part of the BRCA1-associated surveillance complex (BASC), a complex that also contains BRCA1, MLH1, ATM, BLM, PMS2 proteins, and the Rad50-Mre11-NBS1 complex (2). Mutations in MSH6 and other MMR proteins have been found in a large proportion of hereditary nonpolyposis colorectal cancer (Lynch Syndrome), the most common form of inherited colorectal cancer in the Western world (3). Mutations in MSH6 have been shown to occur in glioblastoma in response to temozolomide therapy and to promote temozolomide resistance (4).
N/A